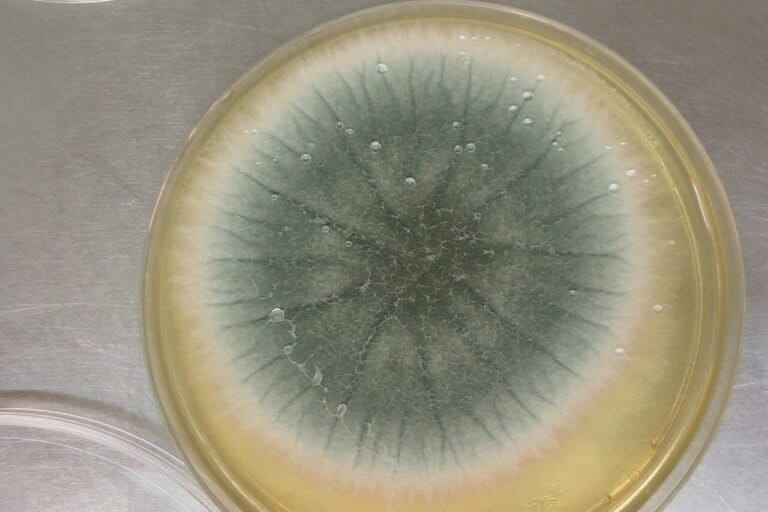
jamur-invasif-yang-menginfeksi-organ-tubuh-menyebar-cepat-seiring-suhu-bumi-yang-memanas

Manusia menghirup ribuan spora jamur setiap harinya tanpa pernah menyadarinya. Sebagian besar spora tersebut melewati tubuh tanpa menyebabkan gangguan kesehatan serius. Namun ada kelompok kecil jamur berbahaya yang kini menyebar luas dan mampu menyerang organ tubuh manusia, merusak ketahanan pangan, hingga mengacaukan ekosistem. Mikroorganisme ini bergerak melintasi batas-batas yang biasanya terpisah. Mereka menghubungkan infeksi di lingkungan rumah sakit dengan kerugian besar pada sektor pertanian serta gangguan lingkungan global. Secara alami jamur memiliki peran penting dalam kehidupan di Bumi karena bertugas mengurai materi mati dan mendaur ulang nutrisi. Sayangnya beberapa spesies mulai menunjukkan sifat yang merusak seiring perubahan kondisi lingkungan. Sejumlah jenis jamur tertentu kini terdeteksi menyebar dari lingkungan medis menuju area pertanian bahkan hingga menyerang koloni serangga. Fenomena ini memperlihatkan betapa tipisnya garis pemisah antara organisme pengurai yang bermanfaat dengan penyerbu yang bersifat merusak bagi makhluk hidup. Pergeseran Ketahanan Akibat Perubahan Iklim Dalam kondisi normal sistem kekebalan tubuh manusia mampu menjaga organisme ini agar tetap terkendali. Namun keseimbangan tersebut saat ini mulai bergeser secara signifikan. Suhu Bumi yang kian menghangat serta penggunaan obat pembasmi jamur atau fungisida yang masif di lahan pertanian menciptakan peluang bagi jamur untuk berevolusi menjadi lebih kuat. Selain itu meningkatnya jumlah pasien dengan kondisi kesehatan rentan memberikan ruang bagi jamur yang lebih tangguh untuk berkembang biak secara agresif di dalam tubuh. Peta distribusi global hasil model MaxENT yang menunjukkan akurasi tinggi dalam menggambarkan penyebaran geografis tiga spesies jamur berbahaya: Aspergillus flavus, A. fumigatus, dan A. niger. Kredit: University of Manchester. Kondisi ini menciptakan realitas baru yang…This article was originally published on Mongabay
Jamur Invasif yang Menginfeksi Organ Tubuh Menyebar Cepat Seiring Suhu Bumi yang Memanas
Jamur Invasif yang Menginfeksi Organ Tubuh Menyebar Cepat Seiring Suhu Bumi yang Memanas



















Comments are closed.